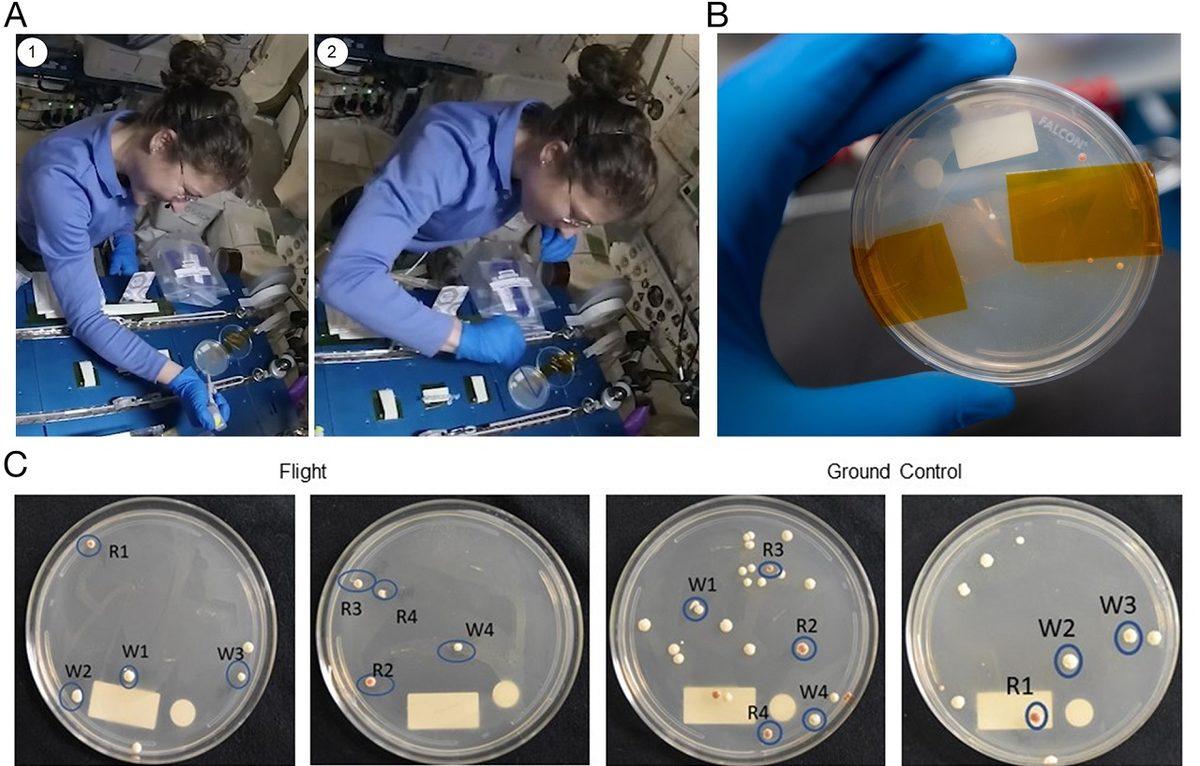
Astronotlar Uzayda Gen Düzenlemeyi İlk Kez Başarılı Şekilde Gerçekleştirdi

Uzayda ultraviyole ışığa ve radyasyona maruz kalmak, DNA hasarlarına yol açabiliyor. Bu durum, uzun vadede astronotların sağlığı için oldukça büyük bir sorun teşkil ediyor. Hem astronotların sağlığı için hem de gelecekte yapılacak tüm insanlı uzay görevlerinde benzer sorunlarla karşılaşmamak adına DNA hasarının önüne nasıl geçilebileceği ile ilgili çeşitli araştırmalar yürütülüyor.
Bu doğrultuda DNA onarımının nasıl gerçekleştirilebileceğine yönelik yapılan bir araştırmada, Uluslararası Uzay İstasyonu'ndaki (ISS) astronotlar oldukça önemli bir deneysel gen düzenleme işlemini başarı ile gerçekleştirdi.
Çalışmalar gelecekte uzay yolculuklarını daha kolay kılacak:
Yürütülen deneysel çalışma kapsamında ISS'de bulunan astronotlar maya hücreleri üzerinde gerçekleştirildi. Çalışma kapsamında önce DNA üzerinde hasar oluşturuldu, ardından da bu hasarın giderilmesi ve dizilimin yeniden gerçekleştirilmesi sağlandı.
Plos One isimli dergide yayınlanan araştırmanın kıdemli yazarı olan Sebastian Kraves çalışmanın önemini vurguladığı açıklamasında "Ekip sadece ekstrem bir ortamda CRISPR genom düzenleme, PCR ve nanopor dizileme gibi yeni teknolojileri başarıyla uygulamakla kalmadı, aynı zamanda bu teknolojileri mikrogravitede DNA onarımı ve diğer temel hücresel süreçlere ilişkin çalışmalarda uygulanılabilen işlevsel olarak eksiksiz bir biyoteknoloji iş akışına entegre edebildi'' şeklinde konuştu.
Geleceğin insanlık için en büyük heyecan yaratan adımlarından biri olan uzay yolculukları için aşmamız gereken tek engel daha güçlü roketler ya da daha akıllı uzay araçları yapmak değil. Aynı zamanda insan vücudunun uzayda olmaya verdiği reaksiyonlara yönelik de çözümler üretmemiz gerekiyor. Bu kapsamda pek çok farklı araştırma yürütülüyor.
Örneğin astronotları zararlı ve hatta ölümcül X-ışını radyasyonundan korumak için doğada tespit edilmemiş bir malzeme ile cilt pigmentlerinden yapılmış bir güneş kremi geliştirildi. Geçtiğimiz haftalarda ise yine ISS'de yürütülen bir başka araştırma sonrası spermin uzayda DNA'sına zarar gelmeden 200 yıl boyunca korunabileceği tespit edilmişti.
